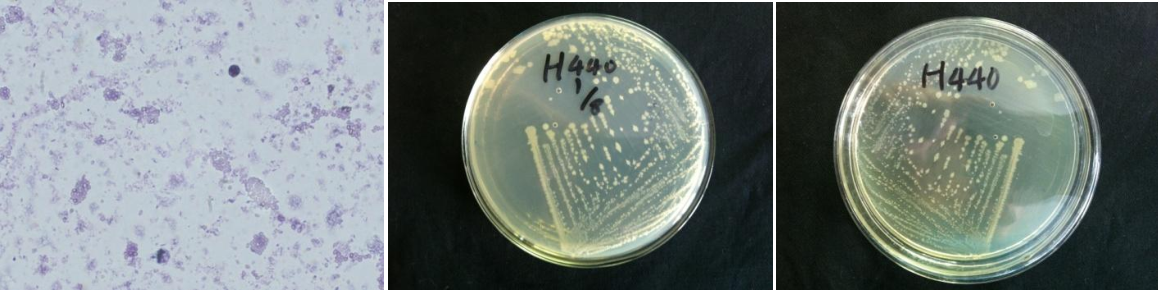

Loading...
| StrainNO | B519 |
| Classification | Bacillus |
| 16s rDNA sequence | AATACATAGCAAGTCGAGCGACAGTGGGAGCTTGCTCCCTGAGGTAGCGGCGGACGGGTGAGAAAGAAGTGGGCAACCTGCCTGT AAGACTGGGATAACTCCGGGAAACCGGGGCTAATACCGGATAATTCATTTCCTCTCATGAGGAAATGCTGAAAGACGGTTTCGGC TGTCACTTACAGATGGGCCCGCGGCGCATTAGCTAGTTGGTGAGGTAACGGCTCACCAAGGCCACGATGCGTAGCCGACCTGAGA GGGTGATCGGCCACACTGGGACTGAGACACGGCCCAGACTCCTACGGGAGGCAGCAGTAGGGAATCTTCCGCAATGGACGAAAGT CTGACGGAGCAACGCCGCGTGAGCGAAGAAGGCCTTCGGGTCGTAAAGCTCTGTTGTTAGGGAAGAACAAGTATCGGAGTAACTG CCGGTACCTTGACGGTACCTAACCAGAAAGCCACGGCTAACTACGTGCCAGCAGCCGCGGTAATACGTAGGTGGCAAGCGTTGTC CGGAATTATTGGGCGTAAAGCGCGCGCAGGCGGTCCTTTAAGTCTGATGTGAAAGCCCACGGCTCAACCGTGGAGGGTCATTGGA AACTGGGGGACTTGAGTGCAGAAGAGGAGAGTGGAATTCCACGTGTAGCGGTGAAATGCGTAGAGATGTGGAGGAACACCAGTGG CGAAGGCGACTCTCTGGTCTGTAACTGACGCTGAGGCGCGAAAGCGTGGGGAGCGAACAGGATTAGATACCCTGGTAGTCCACGC CGTAAACGATGAGTGCTAAGTGTTAGAGGGTTTCCGCCCTTTAGTGCTGCAGCAAACGCATTAAGCACTCTGCCTGGGGAGTACG GGCGCAGGCTGAAACTCAAAGGAATTGACGGGGGCCCGCACAAGCGGTGGAGCATGTGGTTTATTCGAAGCAACGCGATGAACCT TACCAGGTCTTGACATCCTCTGACACCTCTGGAGAACAGAGCTTTTCCCTTTCGGGGGACAGAGTGACCAGTGGGGCATGGTTGT CGTCAGCTCTGTCGTGGAGAAGTTGGGTTAAGTCCGAACCAAGACGCCAACCCTGGTCCTTGATGGC |
| Strain Morphology Photos | |
| Morphological Description |